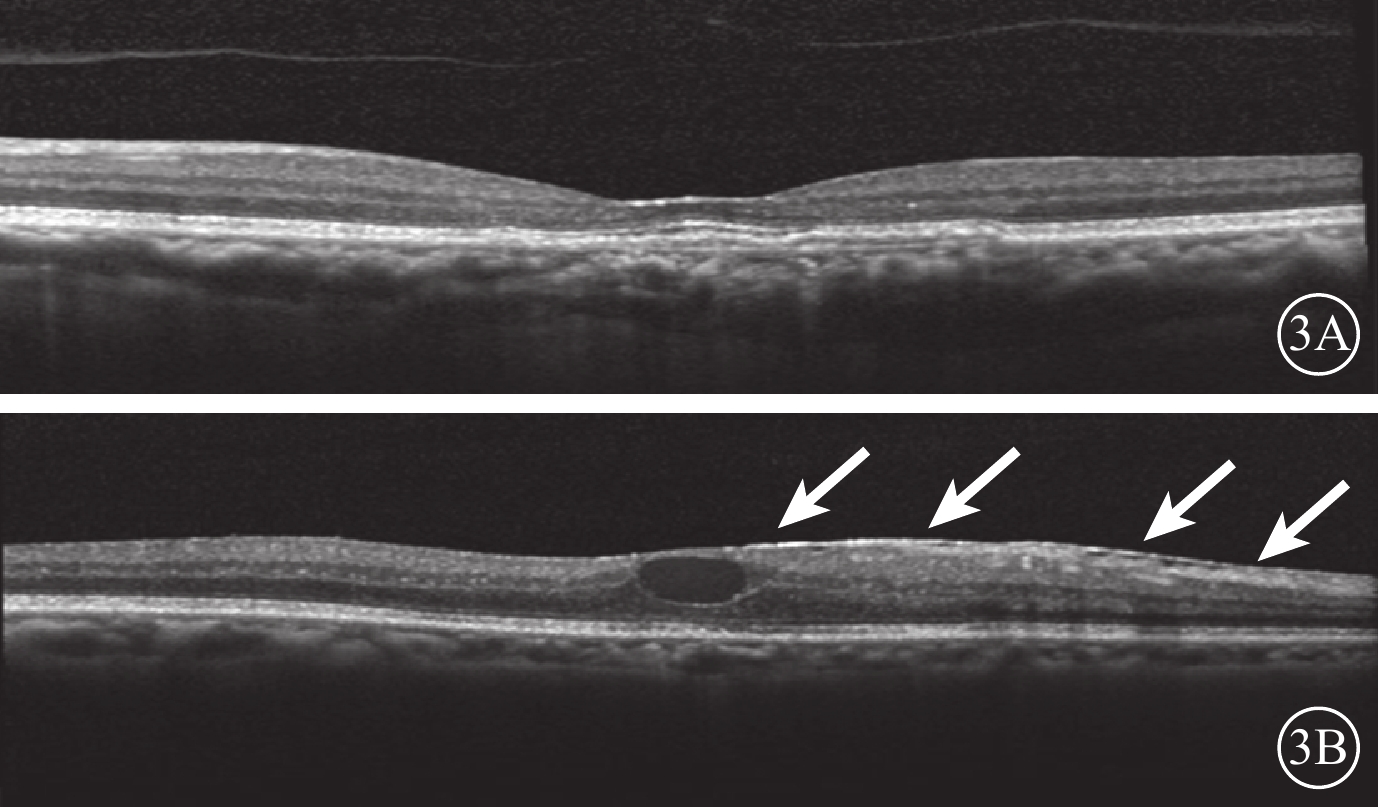

引用本文: 董琪, 華英彬, 徐海峰. 反復抗血管內皮生長因子藥物治療對滲出型老年性黃斑變性患者玻璃體黃斑界面的影響. 中華眼底病雜志, 2018, 34(3): 263-267. doi: 10.3760/cma.j.issn.1005-1015.2018.03.013 復制
玻璃體腔注射抗血管內皮生長因子(VEGF)藥物是治療滲出型老年性黃斑變性(AMD)的一線治療方法,為使患者獲得更好視力,通常需要反復注射[1-10]。玻璃體黃斑界面(VMI)完整性對視功能維持具有重要作用,但其受許多因素影響,其中玻璃體狀態是最重要的因素之一。老化、炎癥、玻璃體積血等均可改變玻璃體的凝膠狀態而產生液化,隨著眼球轉動,液化的玻璃體很容易與視網膜分離,即發生后脫離;在玻璃體后脫離過程中,可能會因為玻璃體視網膜不同程度粘連而發生玻璃體黃斑牽引甚至裂孔,也可因為內界膜損傷誘發黃斑前膜(MEM),從而使VMI的狀態發生改變并影響視功能。已有研究表明,VMI狀態與AMD發生、發展及預后均有一定相關性[11-16];但目前關于反復抗VEGF藥物治療對滲出型AMD患者VMI是否有影響尚不清楚。為此,我們觀察分析了一組滲出型AMD患者經反復抗VEGF藥物治療后VMI的變化情況,現將結果報道如下。
1 對象和方法
回顧性研究。2012年10月至2015年12月在青島眼科醫院接受抗VEGF藥物治療的滲出型AMD患者34例納入本研究。其中,男性26例,女性8例。年齡50~80歲,平均年齡(62.8±8.35)歲。取其1年隨訪期間最少抗VEGF藥物治療6次的眼為研究眼,未接受抗VEGF藥物治療的對側眼為對照眼。
所有患者在接受抗VEGF藥物治療之前均行常規眼前節、眼底彩色照相、熒光素眼底血管造影(FFA)、吲哚青綠血管造影(ICGA)及光相干斷層掃描(OCT)檢查。眼底可見視網膜下或視網膜神經上皮下滲漏、出血、脂質滲出或視網膜色素上皮(RPE)脫離。FFA聯合ICGA檢查,早期見邊界清晰、花邊樣強熒光,滲漏自始至終,晚期顯著。OCT檢查,視網膜整體增厚,黃斑區正常結構改變,RPE連續性破壞,局部增厚隆起,內部反射增強,神經上皮層間及脈絡膜新生血管邊緣可見囊樣改變和視網膜下液。納入標準:(1)年齡≥50歲的滲出型AMD患者;(2)研究眼存在活動性脈絡膜新生血管(CNV)且隨訪1年內至少接受過6次抗VEGF藥物治療;(3)FFA、ICGA及OCT檢查確認研究眼病灶位于黃斑中心凹下方;(4)纖維化總面積不超過總病灶的50%。排除標準:(1)研究眼及對照眼此前接受過抗VEGF藥物治療;(2)存在已知的可影響VMI的情況,如葡萄膜炎、病理性近視、糖尿病視網膜病變及其他視網膜血管病變;(3)接受過玻璃體切割手術、復雜性白內障相關手術;(4)在隨訪期內出現并發眼病。
所有患者均采用3+PRN的方式接受玻璃體腔注射抗VEGF藥物治療。治療前采用OCT觀察患者雙眼的VMI情況。以中心凹為中心,掃描黃斑區,使用高速模式。(1)體積掃描:ART疊加次數9次,97線掃描線,20°×20°;(2)十字掃描:ART疊加次數36次,2線掃描線,20°×20°。將存在玻璃體黃斑粘連(VMA)、黃斑前膜(MEM)、完全性玻璃體后脫離(C-PVD)定義為VMI異常。以玻璃體粘附在中心凹中心3 mm直徑內,但部分玻璃體視網膜分離為VMA;并根據OCT圖像上玻璃體與黃斑部粘附的直徑大小將VMA分為局灶型(≤1500 μm)和廣泛型(>1500 μm)[17]。以鄰近或貼覆在黃斑前、較玻璃體后界膜厚且反射性強的組織為MEM[18]。以玻璃體后界膜高起,與視網膜黃斑無粘附為C-PVD[19-21]。34只研究眼中,存在VMI異常(圖1)12只眼。其中,廣泛型VMA 8只眼,局灶型VMA 3只眼,MEM 1只眼;合并存在局灶型VMA、MEM 1只眼。34只對照眼中,存在VMI異常(圖2)12只眼。其中,廣泛型VMA 7只眼,局灶型VMA 2只眼,C-PVD 2只眼,MEM 1只眼。治療后隨訪觀察12~26個月,平均隨訪時間16.4個月。隨訪期間每月用隨訪模式進行雙眼OCT檢查。對比分析患者雙眼治療前后VMI的變化情況。
 圖1
VMI異常的研究眼OCT像。1A. 黃斑中心凹區域局灶型VMA(白箭);1B. MEM(白箭)
圖1
VMI異常的研究眼OCT像。1A. 黃斑中心凹區域局灶型VMA(白箭);1B. MEM(白箭)
 圖2
VMI異常的對照眼OCT像。2A. 黃斑中心凹區域局灶型VMA(白箭);2B. 黃斑區廣泛型VMA(白箭)
圖2
VMI異常的對照眼OCT像。2A. 黃斑中心凹區域局灶型VMA(白箭);2B. 黃斑區廣泛型VMA(白箭)
采用SPSS19.0軟件進行統計分析。定性數據用數字和百分比進行描述,定量數據用范圍、平均值進行描述。根據末次隨訪時VMI有無變化進行二變量編秩制作2×2列聯表,使用配對χ2檢驗McNemar比較研究眼及對照眼治療前及末次隨訪時的差異,由于樣本數<40,進行Fisher確切概率法分析數據。以P<0.05為差異有統計學意義。
2 結果
末次隨訪時,34只研究眼中,VMI異常12只眼。其中,廣泛型VMA 5只眼,局灶型VMA 2只眼,C-PVD 3只眼,MEM 2只眼;合并存在C-PVD、MEM 1只眼。與治療前比較,共有6只眼VMI發生變化(圖3)。34只對照眼中,VMI異常13只眼。其中,廣泛型VMA 5只眼,C-PVD 7只眼,MEM 1只眼。與治療前比較,共有6只眼VMI發生變化(圖4)。治療前研究眼中局灶型VMA 3只眼,其末次隨訪時發生C-PVD 2只眼。治療前對照眼中局灶型VMA 2只眼,末次隨訪時均發生C-PVD(表1)。
所有研究眼及對照眼中,共有4只眼在末次隨訪時由局灶型VMA變為C-PVD,占總局灶型VMA的80.0%;共有3只眼由廣泛型VMA變為C-PVD,占總廣泛型VMA的21.4%。
研究眼及其相應對照眼VMI變化情況比較,差異無統計學意義(P=0.053)(表2)。
3 討論
本研究結果顯示,VMI變化在研究眼及其相應對照眼之間的差異無統計學意義。說明反復玻璃體腔注射抗VGEF藥物不會顯著誘導C-PVD、VMA及MEM發生,這與Veloso等[22]的研究結果一致。
本研究納入的研究眼及對照眼中,共有4只眼在末次隨訪時由局灶型VMA變為C-PVD,占總局灶型VMA的80.0%;共有3只眼由廣泛型VMA變為C-PVD,占總廣泛型VMA的21.4%。提示局灶型VMA有更高概率發生C-PVD,與Veloso等[22]的研究結果一致。我們還發現,治療前研究眼中局灶型VMA 3只眼,其末次隨訪時發生C-PVD 2只眼;治療前對照眼中局灶型VMA 2只眼,末次隨訪時均發生C-PVD;并且治療前雙眼均有局灶型VMA者在末次隨訪時雙眼均發生C-PVD。提示無論是否接受反復抗VEGF藥物治療,局灶型VMA均有更高概率發生C-PVD。
本研究結果顯示,共有3只研究眼及5只對照眼發生C-PVD。我們推測C-PVD的發生不一定與玻璃體腔注射抗VEGF藥物治療的藥物效應或機械效應相關。一項多中心隨機雙盲研究在注射安慰劑治療的眼中發現,10.1%的患眼在手術后28 d VMA狀態解除,因此他們推測其與玻璃體腔注射的機械效應可能相關,玻璃體腔注射可能會誘發C-PVD改變[23]。本研究與上述結論不同,這可能與兩項研究納入觀察的疾病不同、納入標準不同以及是否設立對照組等差異有關。本研究設置了同一患者的對側眼為對照眼,在對照眼不接受玻璃體腔注藥的情形下,可以對比觀察自然過程對VMI的影響。我們發現,共有6例患者發生C-PVD改變;其中2例為雙眼均發生,1例為研究眼發生,其余3例為對照眼發生。據此推測C-PVD的發生可能是與自然過程相關。
MEM可以繼發于內界膜損傷而形成,包括膠原纖維細胞、RPE細胞、纖維細胞、巨噬細胞以及大量的膠原蛋白。如果MEM內細胞成分收縮,會對視網膜造成切線方向的牽引力,導致視網膜神經上皮結構破壞甚至黃斑裂孔。本研究中,2只研究眼以及1只對照眼在治療前存在MEM,且其在末次隨訪時均發生了MEM增厚;另有1只研究眼在隨訪過程中新發生了MEM。推測MEM可能與滲出型AMD疾病狀態或玻璃體腔注射藥物治療相關。結合雙眼配對情況,1例患者治療前雙眼均有MEM,末次隨訪時雙眼MEM增厚。我們推測MEM也可能與自然過程相關。但由于樣本量較小,以上推測無法計算其統計學意義。未來可加大樣本量以探索MEM與反復抗VEGF藥物治療之間的確切關系。
本研究結果表明,反復抗VEGF藥物治療對VMI無明顯影響;且無論是否反復抗VEGF藥物治療,局灶型VMA較廣泛型VMA更易發生C-PVD。由于玻璃體及VMI受自然過程影響較大,設置配對的對照組十分必要。但由于本研究樣本量較小,有關VMI與反復抗VEGF藥物治療之間的確切關系有待更大樣本量的研究進一步驗證。
玻璃體腔注射抗血管內皮生長因子(VEGF)藥物是治療滲出型老年性黃斑變性(AMD)的一線治療方法,為使患者獲得更好視力,通常需要反復注射[1-10]。玻璃體黃斑界面(VMI)完整性對視功能維持具有重要作用,但其受許多因素影響,其中玻璃體狀態是最重要的因素之一。老化、炎癥、玻璃體積血等均可改變玻璃體的凝膠狀態而產生液化,隨著眼球轉動,液化的玻璃體很容易與視網膜分離,即發生后脫離;在玻璃體后脫離過程中,可能會因為玻璃體視網膜不同程度粘連而發生玻璃體黃斑牽引甚至裂孔,也可因為內界膜損傷誘發黃斑前膜(MEM),從而使VMI的狀態發生改變并影響視功能。已有研究表明,VMI狀態與AMD發生、發展及預后均有一定相關性[11-16];但目前關于反復抗VEGF藥物治療對滲出型AMD患者VMI是否有影響尚不清楚。為此,我們觀察分析了一組滲出型AMD患者經反復抗VEGF藥物治療后VMI的變化情況,現將結果報道如下。
1 對象和方法
回顧性研究。2012年10月至2015年12月在青島眼科醫院接受抗VEGF藥物治療的滲出型AMD患者34例納入本研究。其中,男性26例,女性8例。年齡50~80歲,平均年齡(62.8±8.35)歲。取其1年隨訪期間最少抗VEGF藥物治療6次的眼為研究眼,未接受抗VEGF藥物治療的對側眼為對照眼。
所有患者在接受抗VEGF藥物治療之前均行常規眼前節、眼底彩色照相、熒光素眼底血管造影(FFA)、吲哚青綠血管造影(ICGA)及光相干斷層掃描(OCT)檢查。眼底可見視網膜下或視網膜神經上皮下滲漏、出血、脂質滲出或視網膜色素上皮(RPE)脫離。FFA聯合ICGA檢查,早期見邊界清晰、花邊樣強熒光,滲漏自始至終,晚期顯著。OCT檢查,視網膜整體增厚,黃斑區正常結構改變,RPE連續性破壞,局部增厚隆起,內部反射增強,神經上皮層間及脈絡膜新生血管邊緣可見囊樣改變和視網膜下液。納入標準:(1)年齡≥50歲的滲出型AMD患者;(2)研究眼存在活動性脈絡膜新生血管(CNV)且隨訪1年內至少接受過6次抗VEGF藥物治療;(3)FFA、ICGA及OCT檢查確認研究眼病灶位于黃斑中心凹下方;(4)纖維化總面積不超過總病灶的50%。排除標準:(1)研究眼及對照眼此前接受過抗VEGF藥物治療;(2)存在已知的可影響VMI的情況,如葡萄膜炎、病理性近視、糖尿病視網膜病變及其他視網膜血管病變;(3)接受過玻璃體切割手術、復雜性白內障相關手術;(4)在隨訪期內出現并發眼病。
所有患者均采用3+PRN的方式接受玻璃體腔注射抗VEGF藥物治療。治療前采用OCT觀察患者雙眼的VMI情況。以中心凹為中心,掃描黃斑區,使用高速模式。(1)體積掃描:ART疊加次數9次,97線掃描線,20°×20°;(2)十字掃描:ART疊加次數36次,2線掃描線,20°×20°。將存在玻璃體黃斑粘連(VMA)、黃斑前膜(MEM)、完全性玻璃體后脫離(C-PVD)定義為VMI異常。以玻璃體粘附在中心凹中心3 mm直徑內,但部分玻璃體視網膜分離為VMA;并根據OCT圖像上玻璃體與黃斑部粘附的直徑大小將VMA分為局灶型(≤1500 μm)和廣泛型(>1500 μm)[17]。以鄰近或貼覆在黃斑前、較玻璃體后界膜厚且反射性強的組織為MEM[18]。以玻璃體后界膜高起,與視網膜黃斑無粘附為C-PVD[19-21]。34只研究眼中,存在VMI異常(圖1)12只眼。其中,廣泛型VMA 8只眼,局灶型VMA 3只眼,MEM 1只眼;合并存在局灶型VMA、MEM 1只眼。34只對照眼中,存在VMI異常(圖2)12只眼。其中,廣泛型VMA 7只眼,局灶型VMA 2只眼,C-PVD 2只眼,MEM 1只眼。治療后隨訪觀察12~26個月,平均隨訪時間16.4個月。隨訪期間每月用隨訪模式進行雙眼OCT檢查。對比分析患者雙眼治療前后VMI的變化情況。
 圖1
VMI異常的研究眼OCT像。1A. 黃斑中心凹區域局灶型VMA(白箭);1B. MEM(白箭)
圖1
VMI異常的研究眼OCT像。1A. 黃斑中心凹區域局灶型VMA(白箭);1B. MEM(白箭)
 圖2
VMI異常的對照眼OCT像。2A. 黃斑中心凹區域局灶型VMA(白箭);2B. 黃斑區廣泛型VMA(白箭)
圖2
VMI異常的對照眼OCT像。2A. 黃斑中心凹區域局灶型VMA(白箭);2B. 黃斑區廣泛型VMA(白箭)
采用SPSS19.0軟件進行統計分析。定性數據用數字和百分比進行描述,定量數據用范圍、平均值進行描述。根據末次隨訪時VMI有無變化進行二變量編秩制作2×2列聯表,使用配對χ2檢驗McNemar比較研究眼及對照眼治療前及末次隨訪時的差異,由于樣本數<40,進行Fisher確切概率法分析數據。以P<0.05為差異有統計學意義。
2 結果
末次隨訪時,34只研究眼中,VMI異常12只眼。其中,廣泛型VMA 5只眼,局灶型VMA 2只眼,C-PVD 3只眼,MEM 2只眼;合并存在C-PVD、MEM 1只眼。與治療前比較,共有6只眼VMI發生變化(圖3)。34只對照眼中,VMI異常13只眼。其中,廣泛型VMA 5只眼,C-PVD 7只眼,MEM 1只眼。與治療前比較,共有6只眼VMI發生變化(圖4)。治療前研究眼中局灶型VMA 3只眼,其末次隨訪時發生C-PVD 2只眼。治療前對照眼中局灶型VMA 2只眼,末次隨訪時均發生C-PVD(表1)。
所有研究眼及對照眼中,共有4只眼在末次隨訪時由局灶型VMA變為C-PVD,占總局灶型VMA的80.0%;共有3只眼由廣泛型VMA變為C-PVD,占總廣泛型VMA的21.4%。
研究眼及其相應對照眼VMI變化情況比較,差異無統計學意義(P=0.053)(表2)。
3 討論
本研究結果顯示,VMI變化在研究眼及其相應對照眼之間的差異無統計學意義。說明反復玻璃體腔注射抗VGEF藥物不會顯著誘導C-PVD、VMA及MEM發生,這與Veloso等[22]的研究結果一致。
本研究納入的研究眼及對照眼中,共有4只眼在末次隨訪時由局灶型VMA變為C-PVD,占總局灶型VMA的80.0%;共有3只眼由廣泛型VMA變為C-PVD,占總廣泛型VMA的21.4%。提示局灶型VMA有更高概率發生C-PVD,與Veloso等[22]的研究結果一致。我們還發現,治療前研究眼中局灶型VMA 3只眼,其末次隨訪時發生C-PVD 2只眼;治療前對照眼中局灶型VMA 2只眼,末次隨訪時均發生C-PVD;并且治療前雙眼均有局灶型VMA者在末次隨訪時雙眼均發生C-PVD。提示無論是否接受反復抗VEGF藥物治療,局灶型VMA均有更高概率發生C-PVD。
本研究結果顯示,共有3只研究眼及5只對照眼發生C-PVD。我們推測C-PVD的發生不一定與玻璃體腔注射抗VEGF藥物治療的藥物效應或機械效應相關。一項多中心隨機雙盲研究在注射安慰劑治療的眼中發現,10.1%的患眼在手術后28 d VMA狀態解除,因此他們推測其與玻璃體腔注射的機械效應可能相關,玻璃體腔注射可能會誘發C-PVD改變[23]。本研究與上述結論不同,這可能與兩項研究納入觀察的疾病不同、納入標準不同以及是否設立對照組等差異有關。本研究設置了同一患者的對側眼為對照眼,在對照眼不接受玻璃體腔注藥的情形下,可以對比觀察自然過程對VMI的影響。我們發現,共有6例患者發生C-PVD改變;其中2例為雙眼均發生,1例為研究眼發生,其余3例為對照眼發生。據此推測C-PVD的發生可能是與自然過程相關。
MEM可以繼發于內界膜損傷而形成,包括膠原纖維細胞、RPE細胞、纖維細胞、巨噬細胞以及大量的膠原蛋白。如果MEM內細胞成分收縮,會對視網膜造成切線方向的牽引力,導致視網膜神經上皮結構破壞甚至黃斑裂孔。本研究中,2只研究眼以及1只對照眼在治療前存在MEM,且其在末次隨訪時均發生了MEM增厚;另有1只研究眼在隨訪過程中新發生了MEM。推測MEM可能與滲出型AMD疾病狀態或玻璃體腔注射藥物治療相關。結合雙眼配對情況,1例患者治療前雙眼均有MEM,末次隨訪時雙眼MEM增厚。我們推測MEM也可能與自然過程相關。但由于樣本量較小,以上推測無法計算其統計學意義。未來可加大樣本量以探索MEM與反復抗VEGF藥物治療之間的確切關系。
本研究結果表明,反復抗VEGF藥物治療對VMI無明顯影響;且無論是否反復抗VEGF藥物治療,局灶型VMA較廣泛型VMA更易發生C-PVD。由于玻璃體及VMI受自然過程影響較大,設置配對的對照組十分必要。但由于本研究樣本量較小,有關VMI與反復抗VEGF藥物治療之間的確切關系有待更大樣本量的研究進一步驗證。